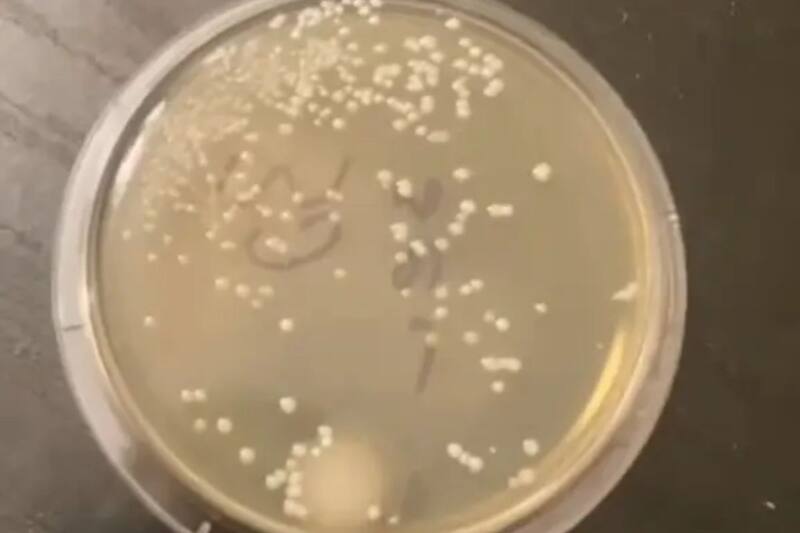

En el mundo hay mitos que se esparcen y se vuelven tan conocidos que todo el mundo los toma como verdad. En esa línea, un científico puso a prueba la famosa "Regla de los 5 segundos" sobre la comida que cae al piso.
En su cuenta de TikTokel experto hizo una sencilla pero categórica prueba. Los resultados dejaron en claro si hay verdad detrás del mito.
Los resultados pueden no ser lo que muchos esperan. Así dieron los resultados de este microbiólogo sobre la famosa regla para la comida.
Experimento pone a prueba la regla de los 5 segundos
El microbiólogo Nicholas Aicher realizó un experimento científico para comprobar si es seguro comer algo que ha caído al suelo. En un video en TikTok, enseño como colocó placas de Petri en el piso durante distintas cantidades de tiempo, desde cero segundos hasta un minuto.

El experto incubó las muestras para observar el crecimiento de bacterias. Los resultados derribaron el mito de la regla de los 5 segundos: la placa de "cero segundos" ya presentaba contaminación microbiana.
Bacterias desde el primer segundo: lo que realmente pasa al comer del suelo
El científico encontró que las muestras de cinco, diez, veinte y treinta segundos tenían niveles similares o mayores de bacterias. Curiosamente, la de un minuto no superaba en crecimiento a la de cinco segundos.
"Ya sea cinco segundos o sesenta, igual será asqueroso", concluyó Aicher. Sus pruebas echan tierra a la idea de que, si algo cae al piso, es seguro comerlo solo y cuándo no pasen cinco segundos.











